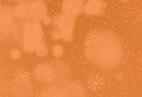

Het is tijd voor iets anders
puzzel n win lekkers van Visspecialist Van der Marel
KPN-gebouw maakt plaats voor woningen
doen p19

De golfbaan van Tespelduyn was tijdens Halloween omgetoverd tot spookbos. | Foto: pr
![]()

KPN-gebouw maakt plaats voor woningen
doen p19

De golfbaan van Tespelduyn was tijdens Halloween omgetoverd tot spookbos. | Foto: pr
GOLFWEDSTRIJD n De Halloween golfwedstrijd voor de jeugd op Landgoed Tespelduyn bleek een spannend succes.
Onder ideale weersomstandigheden werd de wedstrijd gespeeld op de Parkholes, die speciaal waren omgetoverd tot een spookbos. Met glow-in-the-dark ballen, fakkels, gekleurde verlichting en griezelige
De krant niet ontvangen?
All-Inn verspreidingen 0252-241420
Afhaalpunten
Noordwijkerhout/De Zilk:
Gemeentehuis Herenweg 4
Gemeentehuis Herenweg 4
muziek werd een spannende sfeer gecreëerd, compleet met rookmachines en een verdwaalde greenkeeper met kettingzaag.
Paul de Klerk van de jeugdcommissie sprak zijn trots uit: ‘De wedstrijd werd uiteraard in het donker gespeeld, wat het een hele uitdaging maakte om een goede score neer te
zetten.’ Na vier holes bleven er twee teams over met het laagste aantal slagen, wat leidde tot een spannende play-off. Uiteindelijk wisten de ‘Spooky girls’ de winst binnen te halen met een indrukwekkende putt die hen één slag voorsprong opleverde.
Na afloop konden de ouders zelf ervaren hoe uitdagend het was om
in de sfeervolle, duistere omstandigheden te spelen. Onder het genot van een drankje en geroosterde marshmallows werd de bijzondere ervaring nog eens doorgenomen.
Tespelduyn verwelkomt wekelijks meer dan dertig kinderen voor golfles, en biedt jeugdige spelers de kans om de sport op een leuke manier te ontdekken.
VOORSTELLING n Voor de afdeling
Noordwijkerhout van De Zonnebloem gaf theatergroep Raponsel op zaterdag 2 november een feestelijk optreden in het Victorhuis.
aan lekkernijen, waaronder gebak, chocolade, zoutjes en kaasbroodjes, wat de feestelijke sfeer compleet maakte.
De Zonnebloem Noordwijkerhout kijkt terug op een bijzondere dag die veel warmte en blijdschap
bracht aan zowel gasten als vrijwilligers.
GESLAAGD
Dank gaat uit naar alle betrokkenen die hebben bijgedragen aan dit geslaagde evenement.
Burgemeester waarschuwt voor fatbikes
CARNAVAL n Op zondag 10 november is het zover: de Prinsbekendmaking van onze 57e Prins der Duinknijnen en 32e Jeugdprins der Dwergknijnen.
Ze zullen afscheid nemen van onze huidige prinsenparen die plaats gaan maken voor de nieuwe prinsenparen. Er zullen verschillende stunts plaatsvinden waarnaar de nieuwe Prins en Jeugdprins zich bekend zullen maken op het podium. Zien we je in De Duinpan vanaf 12.30 uur.
112 n Vrijdagavond 1 november omstreeks 21.35 uur werd melding gemaakt van een steekincident aan de Maandagsewetering in Noordwijkerhout.
Verschillende hulpdiensten, waaronder een traumateam, werden met spoed opgeroepen. In een woning had zich een conflict in relationele sfeer plaatsgevonden. Daarbij raakte niemand gewond. daarnaast is er geen aanhouding verricht. De politie is een onderzoek gestart naar het incident.
112 n Donderdagmiddag 31 oktober rond 16.15 uur heeft een ongeval plaatsgevonden aan de Provincialeweg N206 in Noordwijk.
VVV Noordwijkerhout Havenstraat 10
VVV Noordwijkerhout Dorpsstraat 8
Solassi Duinschoten 12
St. Munnikewei Via Antiqua 25 Solassi Duinschoten 12
S.O.P Pilarenlaan 4 P1
De krant niet ontvangen?
De voorstelling De Bonte Jaren bracht de gasten en vrijwilligers van De Zonnebloem terug naar de jaren ’60, ’70 en ’80 ter ere van het 75-jarig bestaan van de landelijke Zonnebloem-vereniging.
S.O.P Pilarenlaan 4 P1
De Wijde Blick Camping Schulpweg 60
VOMAR Pilarenlaan P1
De Wijde Blick CampingSchulpweg 60
Vink multimedia Havenstraat 9A
VOMAR Pilarenlaan P1
Munnikewei Via Antiqua 25
Vink multimedia Havenstraat
Gemeentehuis Noordwijk
Gemeentehuis Noordwijk
Bel De Schakel
Super de Zilk Breeland 2A De Zilk
De Spar Breeland 2A De Zilk
0252-241420
Met een afwisselend programma werden de aanwezigen getrakteerd op herkenbare muziek, ochtendgymnastiek en komische sketches die herinneringen opriepen aan vervlogen tijden. Het publiek zong mee met bekende liedjes en genoot van de humoristische en nostalgische sfeer. De middag bood iedereen de kans om even terug in de tijd te gaan en samen plezier te beleven.
Naast de voorstelling werden de gasten verwend met een variatie

Tenminste drie bestelbussen zijn met elkaar in botsing gekomen. De bestelbussen raakte hierdoor beschadigd. De brandweer werd opgeroepen vanwege een brand dit bleek niet het geval, wel heeft de brandweer een controle uitgevoerd. Hoe het ongeval heeft kunnen gebeuren is niet bekend. Voor zover bekend raakte niemand gewond. Het ongeval zorgde nogal voor wat verkeersoverlast.


Week 45 | 2024 pagina 1/2
Denk mee over nieuwe straatnamen in de gemeente Noordwijk
Ben jij geïnteresseerd in de geschiedenis van Noordwijk en wil je meehelpen om de omgeving een naam te geven? De gemeente Noordwijk zoekt een vrijwilliger voor de straatnamencommissie die met een frisse blik wil meedenken over nieuwe straatnamen.
Heb jij een historische kijk? Als lid van de straatnamencommissie denk je mee over nieuwe straatnamen in de gemeente Noordwijk. Je hebt een historische kijk op Noordwijk, Noordwijkerhout en De Zilk en die kennis wil de commissie graag gebruiken bij het bedenken van passende nieuwe straatnamen. De straatnamencommissie komt 2 keer per jaar samen in Noordwijkerhout of online om de nieuwe namen te bedenken.
Vergoeding
Voor je inzet ontvang je per jaar een vergoeding. Ben je geïnteresseerd? Meld je dan vóór 28 november 2024 aan door een e-mail te sturen naar gemeente@noordwijk.nl met in de attentie (onderwerp) Vacature straatnamencommissie. De gemeente Noordwijk kijkt uit naar je reactie!
Hoe voorkom je vallen?

Kom naar een van de gratis bijeenkomsten over hoe je vallen kunt voorkomen! Een val kan grote gevolgen hebben voor je zelfredzaamheid. Het kan er voor zorgen dat je afhankelijk wordt van zorg of dat je leven op andere manieren verandert.
Adviezen, hulpmiddelen en cursussen
Elke 5 minuten komt er iemand van 65 jaar of ouder op de Spoedeisende Hulp na een val. Als je ouder wordt, is de kans om te vallen groter. Omdat je wat minder flexibel bent, kunnen de gevolgen van een val ook ernstiger zijn. Botbreuken of hoofdletsel komen bijvoorbeeld vaak voor. Gemeente Noordwijk wil oudere inwoners helpen om vallen te voorkomen. Dat doen we met adviezen, hulpmiddelen en cursussen.
Bijeenkomst
Tijdens de bijeenkomst praten we over de risico’s van vallen en hoe je dit zo goed mogelijk kunt voorkomen. Ook geven we meer informatie over wat onze valpreventiecursusssen je kunnen bieden.
Informatiebijeenkomsten valpreventie
• Vrijdag 8 november 2024 van 14.30 - 16.30 uur. Locatie Sportpark Duinwetering, Duinwetering 105 Noordwijk.
• Zaterdag 30 november 2024 van 11.00 - 13.00 uur. Locatie Losplaatsweg 8 (De Praktijk) Noordwijk. Je kunt je aanmelden voor een van de bijeenkomsten via de website van noordwijkactief.
Gemeente Noordwijk organiseert Ondernemersontbijt

Van 11 tot 15 november is het de week van de Noordwijkse ondernemers. We sluiten deze af op vrijdag 15 november, de landelijke ‘Dag van de Ondernemer’, met een ondernemersontbijt.
Waardering
We bieden het ontbijt aan als blijk van waardering. Een mooi moment om de kracht van het Noordwijkse ondernemerschap te vieren en ondernemers te verbinden.
“Nummer 1 word je niet alleen” Ondernemers uit Noordwijk, Noordwijkerhout en De Zilk zijn welkom op 15 november 2024 om 7.30 uur in De Volière, Noordwijkerhout. Na een welkomstwoord van burgemeester Wendy Verkleij zal gastspreker Jack Plooij inspireren met zijn verhaal: “Nummer 1 word je niet alleen!”. Een perfecte gelegenheid om in een ontspannen sfeer nieuwe contacten te leggen en ervaringen te delen.
Aanmelden
Wil je erbij zijn? Meld je dan aan vóór 8 november 2024 via noordwijk.nl/ondernemersontbijt, waar je ook het programma kunt vinden.
Eigenaar voertuig met caravan gezocht
De gemeente Noordwijk is op zoek naar de eigenaar van dit voertuig met caravan. Het voertuig staat al langere tijd op de Derk Bolhuisstraat in Noordwijk.


Als de eigenaar zich niet voor 1 december 2024 meldt bij de afdeling Vergunningen, Toezicht en Handhaving (VTH) wordt dit voertuig door bestuursdwang verwijderd. De eigenaar kan contact opnemen via +31 (0)71 3660 000 of via handhaving@noordwijk.nl
Verwijderde objecten worden volgens de AWB gedurende 13 weken opgeslagen in een gemeentelijk depot. Tijdens deze periode kan de eigenaar het voertuig ophalen tegen betaling van de berging- en stallingskosten. Wanneer de eigenaar zich niet meldt, vernietigen we het betreffende object.
Eigenaar kledingbakken gezocht
De gemeente Noordwijk is op zoek naar de eigenaar van deze kledingbakken. Deze kledingbakken staan op het Rederijkersplein te Noordwijk.

Als de eigenaar zich niet voor 26 november 2024 meldt bij de afdeling Vergunningen, Toezicht en Handhaving (VTH) wordt dit object door bestuursdwang verwijderd. De eigenaar kan contact opnemen via +31 (0)71 3660 000 of via handhaving@noordwijk.nl
Verwijderde objecten worden volgens de AWB gedurende 13 weken opgeslagen in een gemeentelijk depot. Tijdens deze periode kan de eigenaar het object ophalen tegen betaling van de verwijderings- en opslagkosten. Wanneer de eigenaar zich niet meldt, vernietigen we het betreffende object.
Toekenning straatnaam/openbare ruimte ‘Breloftveld’
Op 22 oktober 2024 heeft het college van burgemeester en wethouders besloten de naam ‘Breloftveld’ toe te kennen aan het onlangs gerealiseerde landschapspark in Noordwijk. Het park is ingericht als landschapspark en bevindt zich aan de Nieuwe Zeeweg 165. Dit besluit is genomen op basis van artikel 6 Wet BAG en de Verordening Naamgeving en nummering (adressen) Noordwijk 2019. Het besluit ligt gedurende 6 weken vanaf 22 oktober t/m 3 december 2024 ter inzage in het gemeentehuis.
Bezwaar
Belanghebbenden kunnen bezwaar maken. Dat moet in de genoemde periode. Zie voor meer informatie de officiële publicatie.
Vergunningaanvragen, meldingen en verzonden besluiten
In deze rubriek vind je informatie over meldingen, vergunningsaanvragen en verzonden besluiten van de gemeente en de Omgevingsdienst West-Holland.
Gemeente Noordwijk
Verzonden besluiten
Noordwijk
788838 - 29 oktober 2024
2202 GW | Ontheffing sluitingstijd algemeen Beach Club O. Koningin Wilhelmina Boulevard.
793260 - 30 oktober 2024
2202 BK | Ontheffing sluitingstijd incidenteel 28 november en 14 december 2024 Breakers Beach House Koningin Astrid Boulevard.
782736 - 30 oktober 2024
2201 HW | Melding collecte 14 t/m 19 april 2025 Stichting Nationaal Fonds Kinderhulp.
784286 - 30 oktober 2024
2201 HW | Melding collecte 27 januari t/m 1 februari 2025 De Hersenstichting. 790093 - 30 oktober 2024
2201 HW | Wachtlijst weekmarkt Kloosterplein Noordwijk branche dameskleding.
674790 - 31 oktober 2024
2202 CP | Exploitatievergunning Hotel Astoria Emmaweg.
726505 - 31 oktober 2024
2202 CP | Terrasvergunning Hotel Astoria Emmaweg.
Noordwijkerhout
787815 - 30 oktober 2024 2211 HT | Evenementvergunning 17 december 2024 Kerstbelevingstocht Hafakker Strandwal.
Overzicht collectes
In week 45 is er een collecte gepland van Stichting Alzheimer Nederland. In week 46 is er een collecte gepland van Stichting Het Gehandicapte Kind.
Omgevingsdienst West-Holland
Ingekomen aanvragen
Omgevingsvergunning
Noordwijk
2024-014955 - 28 oktober 2024

Herenweg 15 | het vervangen van de dakkapellen op het voor- en achterdakvlak.
2024-015006 - 28 oktober 2024
Parelduiker 55 | het plaatsen van een dakkapel op het achterdakvlak.
2024-015007 - 28 oktober 2024
De Scheysloot perceel I648 | het realiseren van een busremise.
>>
2024-015050 - 29 oktober 2024
Willem-Alexanderpark 46 | het kappen van een boom.
2024-015089 - 29 oktober 2024
Pickéstraat 85 | het plaatsen van een tijdelijke toiletunit.
2024-015080 - 30 oktober 2024
Narcisstraat 12 | het plaatsen van een dakkapel op het voor en achterdakvlak.
Noordwijkerhout
2024-015005 - 28 oktober 2024
Sint Pieterstraat 1 | het plaatsen van een houten overkapping aan een bestaande schuur.
2024-015138 - 30 oktober 2024
Duinhuislaan 37 | het kappen van een boom.
Verlengingsbesluiten
Noordwijk
2024-012790
Hogeweg 33 | het aanleggen van een inrit.
2024-012692
Nieuwe Offemweg 20 | het kappen van een boom.
Verleende besluiten
Noordwijk
2024-012183* - 25 oktober 2024
Van de Mortelstraat 4 | het kappen van 100 bomen.
2024-010767 - 25 oktober 2024
Parelduiker 55 | het plaatsen van een dakkapel op het voordakvlak.
2024-010330 - 25 oktober 2024
De Witte Raaflaan 160 | het uitbouwen
van de recreatiewoning aan de achterzijde.
2024-010644 - 25 oktober 2024
Bos, Zee en Duin 10 | het vervangen van een zomerhuis.
2024-013959* - 29 oktober 2024
Rozenburg 13 | het kappen van een boom.
Noordwijkerhout
2024-010591* - 28 oktober 2024
Westeinde 62 | het kappen van 2 bomen.
2024-010462 - 30 oktober 2024
Heggerank 2 | het plaatsen van een dakkapel op het voordakvlak van de woning.
De Zilk
2024-013830* - 25 oktober 2024
Hoogduinweg 44 | het kappen van een boom.
*voor deze besluiten geldt een uitgestelde inwerkingtreding tot na afloop van de bezwaarperiode
Weigeringsbesluiten
Noordwijk
2024-012761 - 25 oktober 2024
Voorstraat 48 | het kappen van een boom.
2024-014178 - 30 oktober 2024
Picképlein 1 | het kappen van een boom.
Adviescommissie
omgevingskwaliteit (erfgoed en welstand)
Bouwplannen worden op afstand
Gemeenteraadsvergadering dinsdag 5 november Aanvang 19.00 uur (let op: dit is eerder dan gebruikelijk!) in het Atrium van het gemeentekantoor in Noordwijkerhout, Herenweg 4.
Op de agenda staat o.a.: Programmabegroting 2025-2028.
Gemeenteraadsvergadering dinsdag 12 november Aanvang 20.00 uur in het Atrium van het gemeentekantoor in Noordwijkerhout, Herenweg 4.
Op de agenda staat o.a:
• Vacature voor wethouder gemeente Noordwijk
• Vaststellen bestemmingsplan Correctie Zeewaardig, fase 3
De gemeenteraad vergadert in 3 stappen
- Tijdens de beeldvormende commissievergadering halen de raadsleden eerst informatie op. Ze vormen zich een beeld van een onderwerp, bijvoorbeeld aan de hand van een presentatie.
- In de meningsvormende commissievergadering stellen de leden vragen aan de verantwoordelijke wethouder, ze gaan met elkaar in debat en bepalen hun standpunt.
- Ten slotte neemt de gemeenteraad tijdens de gemeenteraadsvergadering een besluit over het onderwerp.
Kom inspreken over een onderwerp op de agenda
U heeft het recht tijdens de commissievergaderingen in te spreken over een onderwerp dat op de agenda staat. Als u van uw spreekrecht gebruik
(digitaal) beoordeeld. De eerstvolgende vergaderingen van de adviescommissie omgevingskwaliteit voor afspraken zullen plaatsvinden op woensdag 6 november 2024.
Beschikking maatwerkvoorschriften sloopen bouwwerkzaamheden Raadhuisstraat 9 te Noordwijk
De Omgevingsdienst West-Holland maakt met toepassing van artikel 7.23, lid 1 onder a van het Besluit bouwwerken leefomgeving het volgende bekend. Op grond van het gestelde in artikel 7.23, lid 1 van het Besluit bouwwerken leefomgeving zijn maatwerkvoorschriften gesteld aan Zwanenburg Sloopwerken B.V. De maatwerkvoorschriften zijn ten behoeve van sloop- en bouwwerkzaamheden in de avond ten behoeve van de verbouwing van de Dirk van den Broek supermarkt aan de Raadhuisstraat 9 te Noordwijk.
De maatwerkvoorschriften zijn gesteld voor het uitvoeren van de werkzaamheden op:
• Maandag 21 oktober en dinsdag 22 oktober 2024 in de avondperiode tot 22.00 uur.
• Woensdag 23 oktober 2024 tot en met dinsdag 5 november 2024 in de avondperiode tot 22.00 uur, uitgezonderd de weekenden.
Bent u het niet eens met onze beschikking?
Bent u het niet eens met ons besluit?
Dan kunt u een bezwaarschrift indienen. Dat doet u binnen zes weken na de dag van de bekendmaking van dit besluit. Wij verzoeken u het zaaknummer hierbij te vermelden. U kunt het bezwaarschrift versturen op de volgende wijzen: per post naar het college van burgemeester en wethouders van de gemeente Noordwijk, per adres Omgevingsdienst West-Holland, Postbus 159, 2300 AD Leiden; per e-mail naar bezwaarschrift@odwh.nl
Persoonlijke e-mailadressen van medewerkers staan niet open voor het ontvangen en in behandeling nemen van bezwaarschriften.
Heeft u bezwaar gemaakt? En is er spoed?
Per adres Omgevingsdienst West-Holland, Postbus 159, 2300 AD Leiden.
Heeft u nog vragen?
Als u meer informatie wilt, dan kunt u contact opnemen met de Omgevingsdienst West-Holland. Dit kan via +31 (0)71 4083 100 of info@odwh.nl. Noem hierbij het zaaknummer: 2024-014501.
Ingekomen melding milieubelastende activiteitRuigenhoekerweg in Noordwijkerhout
De Omgevingsdienst West-Holland heeft op 21 oktober 2024 een melding ontvangen. De melding is ingediend voor het starten van een milieubelastende activiteit op de locatie Ruigenhoekerweg in Noordwijkerhout. Deze melding is geregistreerd in het Omgevingsloket onder verzoeknummer 2024102101712.
De melding gaat over het toepassen van grond of baggerspecie.
Geen bezwaar/beroep Het is niet mogelijk om bezwaar te maken of beroep in te stellen tegen deze melding.
Meer informatie
Als u meer informatie wilt, dan kunt u contact opnemen met de Omgevingsdienst West-Holland. Dit kan via +31 (0)71 4083 100 of info@odwh.nl. Noem hierbij het zaaknummer: 2024-014565.
@noordwijkzh /gemeentenoordwijk /gemeentenoordwijk
versie noordwijk.nl/gemeenteberichten
wilt maken, meldt u zich dan binnen 24 uur voor aanvang van de vergadering aan bij de griffie. Dat kan via telefoonnummer +31 (0)71 3660 429 of via griffie@noordwijk.nl Inspreken is niet meer mogelijk bij de gemeenteraadsvergadering.
Andere vragen aan de raad U kunt bij de griffie terecht als u de gemeenteraad wilt bereiken over een onderwerp dat niet op de agenda van een commissie staat of voor andere vragen over de raad.
Agenda en kijk live mee De actuele agenda en stukken vindt u op de website. U kunt de vergaderingen rechtstreeks online volgen of later terugkijken via noordwijk.bestuurlijkeinformatie.nl
Volgt u de gemeenteraad al op X of Instagram?
Als dat zo is, dan kunt u vragen om een voorlopige voorziening bij de voorzieningenrechter van de rechtbank Den Haag. Dit betekent dat de rechter kan bepalen dat de beschikking nog niet ingaat. Deze beslissing geldt dan totdat er naar uw bezwaarschrift is gekeken.
U stuurt uw verzoek om voorlopige voorziening naar: De voorzieningenrechter van de rechtbank Den Haag Sector bestuursrecht, Postbus 20302, 2500 EH DEN HAAG
U kunt uw verzoek ook digitaal indienen. Dit doet u bij de rechtbank Den Haag, via loket.rechtspraak.nl/bestuursrecht Hiervoor heeft u wel een elektronische handtekening (DigiD of eHerkenning) nodig. Op de genoemde website vindt u meer informatie.
Wij vragen u om een kopie van uw verzoek om voorlopige voorziening te sturen naar: Het college van burgemeester en wethouders van de gemeente Noordwijk.
Voor meer informatie over de producten en diensten en de openingstijden van de gemeente: noordwijk.nl
Contact met de gemeente
Bel +31 (0)71 36 60 000 (werkdagen 08.30 - 17.00 uur) of e-mail: gemeente@noordwijk.nl
Maak een afspraak via noordwijk.nl/afspraak of kijk voor alle zaken die je direct digitaal kunt regelen op noordwijk.nl
Ook via sociale media bereikbaar @noordwijkzh facebook.com/gemeentenoordwijk instagram.com/gemeentenoordwijk
De gemeente Noordwijk is niet aansprakelijk voor de redactionele inhoud van deze krant.
Aanleveren familieberichten
U kunt aanleveren via e-mail, post of afgeven bij onze receptie.
Per e-mail
Mail de tekst naar advertentie@uitgeverijverhagen.nl o.v.v. De Noordwijker. U krijgt van ons een geheel vrijblijvende prijsopgave en een voorbeeld (PDF).
Per post of afgeven U kunt uw advertentie per post sturen of afgeven aan onze receptie van Uitgeverij Verhagen, Ambachtsweg 7a, 2222 AH te Katwijk (ma-vr: 8.30-17.00 uur).
(zie voor de sluitingstijd de colofon elders in deze krant)
Wat je in je hart bewaart, raak je nooit meer kwijt
Marijke Nulkes-Brama
1953 - 2009
Voor altijd in ons hart
Jan, Kim, Els en Loes

Wij geven u kennis van het overlijden van
Arnoldus Andries van Dorssen
Noordwijk
3 april 1956
30 oktober 2024
Namens de familie van Dorssen, Tineke en Rinke
Voorstraat 105
2201 HR Noordwijk
De uitvaart van Nol heeft in kleine kring plaatsgevonden.

“Ons familiebedrijf verzorgt het afscheid met liefde” Voor iedereen voor alle verzekeringen en voor leden van een vereniging
U kunt ons dag en nacht bereiken: 0252 - 37 69 42 06 - 19 27 98 21
“Ieder leven is uniek, en zo benader ik ook elke uitvaart. Hierdoor kunnen we samen een afscheid creëren dat uniek is. Uw herinneringen vormen de basis van een passend en hartverwarmend afscheid” Alexander Meijers

Sint Jeroensweg 2a 2201 NW Noordwijk 06 18 21 82 82 info@waardiguitvaart.nl
www.waardiguitvaart.nl

Noordwijkerhout - Noordwijk
Voor een goed verzorgde begrafenis of crematie (ook voor niet-leden)
0252 411 366 info@uitvaartzorgbollenstreek.nl 24/7
Uitvaartzorg Bollenstreek verzorgt de uitvaarten voor St. Barbara
Een afscheid zoals u dat wilt

Weet u wat u allemaal moet regelen en wat een uitvaart kost? Elke maandag (10.00-11.00 uur) is er een inloopspreekuur.
Vraag gratis het wensenboekje ‘Nu voor later’ aan.
Heereweg 21, 2161 AC Lisse 0252 – 413 213 | info@vanderputtenendunweg.nl vanderputtenendunweg.nl


De gemeente Noordwijk nodigt ondernemers uit de gemeente uit voor een ondernemersontbijt. Vrijdag 15 november is de landelijke ‘Dag van de Ondernemer’. Het gemeentebestuur van Noordwijk hecht veel waarde aan de belangrijke rol die ondernemers spelen in Noordwijk, Noordwijkerhout en De Zilk. Daarom nodigen wij alle ondernemers uit onze gemeente van harte uit voor een ontbijt. Een moment om onze waardering te tonen, maar vooral om stil te staan bij de kracht van ondernemerschap, verbinding en samenwerking.
Gastspreker Jack Plooij zal de aanwezigen de aanwezigen gaan inspireren met zijn verhaal: ‘Nummer 1 word je niet alleen!’. Hij deelt zijn waardevolle inzichten en ervaringen over de kracht van samenwerken. Een energiek verhaal dat u zeker niet wilt missen!
Inloop: 07:30 uur, start bijeenkomst 8:00 uur. Locatie De Volière,

Duinschooten 12-335 (aan het Oosterduinsemeer) in Noordwijkerhout.
Wil je je aanmelden of meer weten over het programma? Kijk dan op onze website: www.noordwijk.nl/ondernemersontbijt
Bij de laatste actie van de Partij van de Inwoners, het opzeggen van steun aan het raadsakkoord en aan het huidige college van B&W, kreeg ik direct het beeld van een kwajongensstreek. De definitie van ‘kwajongens ‘is niet helemaal genderneutraal maar is het betitelen van jongens en meisjes, zoals mijn opa het noemde ‘snotneuzen’, die wel wat ondeugend zijn, maar bepaald nog niet misdadig. ‘Onvolwassen’ hoort er ook een beetje bij.
Die genoemde kwajongensstreek is een brief aan raad en college waarin een lange lijst Van PvdI-frustraties publieke wordt gemaakt.
De basis blijkt toch het buitengewoon onfatsoenlijk handelen van de politiek richting de PvdIkandidaat-wethouder bij de wethoudersverkiezingen van vorig jaar. Maar in de 2.200 woorden tellende brief, jawel ‘twee-entwintighonderd’ wordt ‘even snel uitgelegd dat de PvdI het op alle belangrijke thema’s oneens is met het beleid van gemeenteraad en college van B&W.
U merkt dat ik er geen 2.200 worden voor nodig heb, maar ik ben dan ook geen politicus. En ik neem de politiek in onze fusiegemeente ook niet meer zo serieus als ik dit ooit deed. Daarvoor zijn er de afgelopen jaren te veel incidenten geweest die mijns inziens getuigen van onbekwaamheid en het ontbreken van goede wil om het beste voor de inwoners te bereiken. Kortzichtigheid, eigen belang, werken aan herverkiezing en onfatsoenlijkheid domineerden bij de meeste partijen en raadsbrede positieve zakelijke politiek heb ik nauwelijks kunnen herkennen.
Het verbaast me dan ook niet dat gruizige politici nu de opvallende brief van de PvdI, in een 30 minuten durende sessie tijdens de raadsvergadering, in het openbaar aan de orde willen stellen. Deze onverstandige keuze werpt zijn schaduwen nu al vooruit. De regionale pers zit bij voorbaat al te smullen. Lokale politiek op zijn breedst. Duidelijk is dat de komende wethoudersverkiezing opnieuw in het teken zal staan van rancune.
Waarbij een van de twee kandidaten met de staart tussen de poten het veld zal moeten ruimen. Ik meen het gegniffel van de snotneuzen al te kunnen horen als in navolging van de PvdI nog meer partijen de kant kiezen van Mr Hans.
Zodat de officiële VVD-kandidaat, net als de PvdI-kandidaat, zonder bloemen huiswaarts zal moeten keren.
Voor politiek Noordwijk gaat het misschien om een kwajongensstreek, maar daar is in mijn opinie de lokale politiek toch te ernstig voor. En hecht ik te veel waarde aan fatsoen en het met respect omgaan met mensen.
Het lokale belang is toch het realiseren van belangrijke politieke doelen zoals woningbouw, werkgelegenheid, bedrijfsklimaat en inwonerswelzijn?
De Noordwijkse politiek plaatst zich nu opnieuw in de schijnwerpers. En voldoet aan het bestaande beeld dat het in de Noordwijkse politiek ‘altijd een zootje’ is. Kennelijk een mooie kans om ‘in de krant’ te komen. Maar zeg nu zelf, dit zijn toch geen kwajongenstreken meer? Dit is toch slecht voor Noordwijk?
POLITIEK n Het hoe en waarom de Greenpoort Ontwikkeling Maatschappij in het leven is geroepen en hoe het GOM in de praktijk functioneert, staat met zekere regelmaat op de agenda van de Noordwijkse politiek.
Door Wim Siemerink
Ook deze keer was directeur Onno Zwart weer eens uitgenodigd om uitleg te komen geven. Deze keer naar aanleiding van vragen over het jaarverslag van vorig jaar. Onno Zwarts moest de commissie er opnieuw aan herinneren dat de werkwijze van de GOM is vastgelegd in de Intergemeentelijke structuurvisie Duin en Bollenstreek. Hij bracht ook de uitgangspunten nog eens duidelijk onder de aandacht.
DUIDELIJKE SPELREGELS
De gezamenlijke gemeenten willen onder andere geen verdere verstedelijking van het buitengebied en vooral de verrommeling opruimen door herstructurering. Dus gericht op het afbreken van oude en verouderde bedrijfsgebouwen zoals schuren en kassen. En dan zo nodig het uitplaatsen van de betrokken bedrijven.
Belangrijk uitgangspunt is ook het behoud van het huidige bollenareaal. Het GOM werkt via duidelijke maar specifieke regels aan de hand van een bekostigingsmodel.
De gemeenten zijn de aandeelhouders en de herstructureringsbegroting is de basis voor uitvoering van de GOM-activiteiten. Waarbij nieu-

we ontwikkelingen op bollengrond via een heffing per vierkante meter voor de nodige inkomsten moeten zorgen.
LOKALE OVERHEDEN
De directeur benadrukte dat het de lokale overheden zijn die verantwoordelijkheid dragen voor het beleid wat betreft Greenportwoningen, bollengrondcompensatie en herontwikkeling binnen het gebied.
En dat de GOM alleen in het leven is geroepen om dit beleid uit te voeren.
Hij bestreed de misvatting dat GOM gebieden aan kan wijzen die opnieuw ontwikkeld moeten worden.
Zwart: ‘Als een eigenaar niet mee wil werken dan wordt er echt niets opgeruimd.’ Daardoor kan het gewenste opruimpotentieel per maand veranderen, waarmee ook de begrote financiering veranderd.’
VEEL VRAGEN
Via een duidelijke beeldpresentatie nam de directeur de politiek nog eens mee in de bestaande politieke doelen en de inmiddels door de GOM gerealiseerde projecten. En gaf daarbij uitgebreid de antwoorden op de vele vragen vanuit de commissie. Waarbij steeds opnieuw moest worden uitgelegd dat het politieke beleid van de gezamenlijke gemeenten, de basis vormt voor uitvoering van de diverse GOM-taken.
POLITIEK n Deze week besprak de politiek het collegevoorstel om een verklaring van geen bedenkingen af te geven voor tijdelijke huisvesting van maximaal tien alleenstaande statushouders in Trampoline II aan de Schippersvaartweg in Noordwijkerhout.
Door Wim Siemerink
In de commissie Ruimte leek dit even een politiek issue te worden. Met name GroenLinks kwam met een aantal vragen. Belangrijk daarbij bleek de status van het bestemmingsplan en Louis Koppel stelde vooral vragen over een bijbehorende omgevingsvergunning. Die niet goed in elkaar zou zitten wat betreft de functie en de bij die functie
horende wettelijke consequenties.
Wethouder Kortleven reageerde geruststellend: ‘Het gaat vanavond niet om de omgevingsvergunning. We bespreken de tijdelijke huisvesting. Vorig jaar heeft de gemeenteraad al besloten dat er Trampoline II een bestemming kreeg voor ‘tijdelijke huisvesting van vluchtelingen uit Oekraïne en andere doelgroepen’. Het college wil nu de aanwezige leegstand benutten om de achterstand op de taakstelling van het huisvesten van statushouder in te lopen.
De wethouder verduidelijkte dat hij even correct wilde terugkomen op het al genomen besluit van vorig jaar. Om het benutten van de huidige leegstand uit te leggen en
van de politiek te vernemen of er bedenkingen zouden bestaan. Kortleven verder: ‘Het gaat er dus om dat we de bestaande overcapaciteit benutten om er 10 statushouders te huisvesten. We moeten in Noordwijk totaal nog 16 van de 124 statushouders huisvesten om aan onze taakstelling te voldoen. Het college wil nu van u dus de mogelijkheid hebben om er hier 10 te huisvesten.’
De wethouder benadrukte nog eens de tijdelijkheid van de bestemming en dat Trampoline II maximaal 10 jaar mag worden benut. Maar dat de statushouders, volgens in de regio geldende afspraken, binnen 2 tot 5 jaar voor een reguliere woning in aanmerking komen.
Ivar Krüse (PvdI) reageerde nog als enige van de overige fracties met: ‘Goed dat we proberen de achterstand op huisvesten van Statushouders snel in te halen. Zijn pleidooi, dat statusouders vervolgens ook op de wachtlijst van de woningcorporaties zouden moeten komen, was tevergeefs. Omdat Noordwijk de afspraken heeft na te leven dat statushouders wel voorrang op permanente huisvesting moeten krijgen omdat de gemeente verplicht is aan de taakstelling te voldoen.
De commissieleden waren in grote meerderheid tevreden met de uitleg van de wethouder en dus gaat het voorstel gaat als hamerstuk naar de raadsvergadering
POLITIEK n Als het aan het college ligt dan wordt de voormalige telefooncentrale van KPN, dat nu nog staat tegenover de Lidl op de hoek van de Susanne van Ettenstraat en de Adr. Mouritszweg, op korte termijn afgebroken.
Door Wim Siemerink
Het oude gebouw moet plaats te maken voor een wat kleiner gebouw voor KPN en daarnaast voor
24 snel te realiseren woonunits. Appartementen met oppervlakte variërend van 40 m2 tot 70m2. Met volop ruimte voor groen en voortuinen.
Aan de politiek wordt deze week gevraagd om te beginnen met medewerking te verlenen om het bestemmingsplan zo te wijzigen dat de plannen kunnen worden uitgevoerd. De nieuwe plannen overschrijden het bestemmingsplan
qua bouwhoogte want er komt een deel met 4 bouwlagen wat reikt tot 13 meter hoogte.
De parkeeroplossing blijkt op eigen terrein te kunnen worden gerealiseerd. Het plan voldoet volgens het collegevoorstel aan de regels van de Woonvisie met voldoende sociale huurwoningen en ook middelbare huur en middeldure koop. Het college ziet in de realisatie ook de perfecte aansluiting op de om-
geving en stelt dat het Rederijkersplein met de realisatie van dit plan ‘wordt afgemaakt’.
Men is kennelijk van gedachte dat dit in het geheel geen politieke problemen zal opleveren want de agenda geeft aan dat er direct zowel beeldvormend als meningsvormend over zal worden gesproken. Zodat het ook snel als hamerstuk naar de gemeenteraad zal kunnen gaan.


ZAKELIJK n Hun keuze is weloverwogen. Tóch zullen Wim en Dorine Kaptein aan het einde van dit jaar afscheid nemen van Kaptein Orthopedie. Dan dragen zij hun taken vol vertrouwen over binnen het familiebedrijf waarin zij met heel veel plezier hebben gewerkt. “Tijd voor andere dingen”, vinden ze.
Al sinds 1 januari 2023 maakt Kaptein Orthopedie deel uit van Eqwal, een van oorsprong Frans familiebedrijf dat in vele landen actief is in de hulpmiddelenzorg. “Caring for all. Dat is de slogan van Eqwal”, vertelt Wim. “En dat zegt veel! Wij merkten
destijds al snel dat patiëntenzorg er elke dag hoog in het vaandel staat.”
“Dus dat voelde goed. Bovendien blijft Kaptein Orthopedie gewoon Kaptein Orthopedie, zoals al jaren, in Noordwijkerhout en Heemstede,” vult Dorine aan.
“Ook het ‘familiebedrijfgevoel’ dat al bijna 40 jaar in het DNA van al onze medewerkers zit, verdwijnt niet zomaar. De 3e generatie van de familie is bovendien actief in het bedrijf”. Kortom: uw voeten blíjven in goede handen!
“Met enige weemoed, maar vooral
met trots én met een gerust hart dragen wij onze verantwoordelijkheden over”, aldus Wim Kaptein. Het geweldige en deskundige team blijft gewoon en staat ook na hun afscheid voor hun klanten klaar. En het gaat goed met het bedrijf, dus ze kunnen wel extra versterking gebruiken.
Momenteel zoekt Kaptein Orthopedie een administratief medewerker én een medewerker voor in de werkplaats.
Kijk daarom eens op de website www.kaptein-orthopedie.nl of bel met Kaptein Orthopedie, (0252) 34 04 61.
WANDELEN n De inschrijving voor de 4e editie Duin en Bollen Vierdaagse, die gehouden wordt van 16 tot en met 19 oktober 2025, is geopend. Van nu tot 1 januari ontvangt iedere inschrijver automatisch 25 procent kor-
ting. Inschrijven kan voor de 4-daagse, 3-daagse, 2-daagse en een 1-daagse op de website db4daagse.nl.
De Duin en Bollen Vierdaagse heeft in de eerste drie edities wel bewe-
zen dat het jonge evenement potentie heeft om groter te worden. Gezellig is het al en vooral ook goed georganiseerd. En wat een sfeertje ontstond er in oktober onder de wandelaars.
Dus schrijf je in.

U en de gemeenteraad
De 27 gemeenteraadsleden zijn door u, de inwoners van Noordwijk, gekozen om u te vertegenwoordigen. Ze nemen besluiten over beleidsvoorstellen van de burgemeester en wethouders. En ze controleren of zij dit goed uitvoeren.
Wie, wat, waar?
De raadsleden horen graag uw mening en ideeën. Op de webpagina over de gemeenteraad staat wie de Noordwijkse raadsleden zijn en hoe u ze kunt bereiken. Daar vindt u ook wat er op de agenda van de raad staat. En u leest hoe u invloed kunt uitoefenen op plannen van de gemeente.




Keurslager koopje:


Runder Gehakt (prijs per kilo € 8,25!) iedere 2e 500 gram voor de halve

Vleeswarenkoopje:
Gebraden gehakt diverse soorten 2x 100 gram
Special:
Cool kool
100 gram
Varkensdeeg met gehakte noten omwikkeld met een blad groene
Extra koopje:
Boutique ballen 4 stuks
Onze eigen gehaktballen maar dan met een extra kruiden twist.
Meal deal van de week:
Bami met kipsaté
Krijn van der Bent Keurslager Noordwijk Geldig
Zondag 20 september vieren wij ons 10-jarig
500 gram
keurslagerschap een feestelijke open dag, u bent van harte welkom!
Krijn van der Bent keurslager
Gourmet, barbecue en catering Kerkstraat 50, Noordwijk T 071-3612720

Banketbakkerij




Bekijk de nieuwe foto’s op onze internetsite: www.vanderbent.keurslager.nl
Alex van der Holst Kerkstraat 45 2201 KL Noordwijk T 071-3612067 www.alexvanderholst.nl
Reclame van 4 t/m 9 november
Reclame 7 t/m 12 september
€5,00
Heerlijk roomboter speculaas!!!!
Slagroomsoesjes per 100 gram
Zodra de Sint in het land is hebben wij weer volop Sintlekkernijen.
Suikerbeesten, speculaas poppen, roomboter amandel letters en staven, roomboterplaat etc.
€ 2,00
U kunt uw chocoladeletters bij ons bestellen, wij pakken ze dan netjes voor u in.
Wilt u uw relaties of medewerkers verrassen, wij maken graag een offerte voor u!
VALPREVENTIE n Gemeente
Noordwijk organiseert gratis bijeenkomsten om ouderen bewust te maken van valrisico’s en manieren om vallen te voorkomen. Tijdens de bijeenkomsten wordt ingegaan op veelvoorkomende oorzaken en wordt advies gegeven over hulpmiddelen en cursussen die kunnen helpen om de kans op vallen te verkleinen.
Elke vijf minuten belandt er iemand van 65 jaar of ouder op de spoedeisende hulp na een val. Naarmate mensen ouder worden, neemt de kans op vallen toe, mede doordat flexibiliteit afneemt en de gevolgen van een val, zoals botbreuken of hoofdletsel, ernstiger kunnen zijn.
De gemeente biedt praktische ad-
viezen, hulpmiddelen en cursussen aan om ouderen te ondersteunen bij het voorkomen van valincidenten.
INFORMATIE EN AANMELDING
De bijeenkomsten behandelen onder andere de risico’s en preventiemogelijkheden rondom vallen. Er wordt ook informatie gegeven over de valpreventiecursussen die de gemeente aanbiedt. Inwoners kunnen zich aanmelden voor een van de bijeenkomsten via de website van Noordwijk Actief.
DATA EN LOCATIES
Vrijdag 8 november van 14.30 tot 16.30 uur, Sportpark Duinwetering, Duinwetering 105, Noordwijk. Zaterdag 30 november van 11.00 tot 13.00 uur, Losplaatsweg 8 (De Praktijk), Noordwijk.










Voorstraat 23
2225 EK Katwijk aan Zee
+31 71 88 957 22
+31 653 785 106 info@kleenedelmetalen.nl



Onze specialisten zullen uw edelmetalen met eerbied en deskundigheid op waarde schatten. Vervolgens ontvang t u van ons geheel vrijblijvend een aanbo d om de materialen te verkopen.
Goud
Zilver
Munten en baren
Diamanten
Luxe merk horloges
Tanden goud



















Wij hebben het grootste assortiment Cobi constructie speelgoed. Bouw de toekomst en het verleden met Cobi. Van supersnelle straaljagers tot iconische oldtimersCobi heeft het allemaal.


Voor onze poppenmoeders hebben wij een brede collectie aan poppen, kleding en accessoires





Begin je meesterwerk met POSCA Paint Markers. Nu bij ons verkrijgbaar!







LEGO






Wij bieden een breed assortiment aan LEGO. Als je de nieuwste legosets zoekt zit je bij ons aan het goede adres. Poppen









Nieuw in ons assortiment: Balody! Nanoblocks om leuke 3-D bouwprojecten te maken





















































Aanvang 19.00 uur
Aanvang 19.00 uur
Van 18.30 uur tot 23.00 uur
Aanvang 19.00 uur

Deze avond Frans georiënteerde gerechten waarbij Beaujolais primeur geschonken wordt.





































Designkeukens, landelijke keukens, een massief houten keuken of liever een super matte keuken; ik ga samen met u uw ideale keuken ontwerpen.
Dit ontwerp wordt pas gerealiseerd als we goed over ieder detail nagedacht hebben en u helemaal tevreden bent. Dat is onze werkwijze. Ook leveren wij de bijpassende keukenapparatuur van alle topmerken.
Speciaal voor mensen met zeer specifieke wensen kan ik de keuken ook in eigen
‘Des Collations
Des Collations’
Paté “la rame”, Charcuterie, Champignon gratin, Steak tartare ***Tussengerecht***
Deze avond Frans georiënteerde gerechten waarbij Beaujolais primeur geschonken wordt.
***Hoofdgerecht***
Haricots verts & Pommes Boulanger
Paté “la rame”, Charcuterie, Champignon gratin, Steak tartare ***Tussengerecht*** Franse uiensoep met Edammer ***Hoofdgerecht*** Hertenrug=ilet saus “beaujolais” Haricots verts & Pommes Boulanger ***Dessert***

Deze avond serveren wij heerlijke Frans georiënteerde gerechten waarbij wij de Beaujolais primeur, tapbier, huiswijn en/of frisdranken schenken.
Clafoutis aux cerices “kersengebak met vanille ijs”
Kaarten verkrijgbaar bij: Brasserie Havenkwartier Rogstraat 2 in Katwijk Tel. 071-5294922
Vin: Beaujolais primeur 2019
Clafoutis aux cerices “kersengebak met vanille ijs” 071-5294922 reserveringen@brasserie-havenkwartier.nl





€ 57,50 p.p. 071-5294922 reserveringen@brasserie-havenkwartier.nl
Hertenrug=ilet saus “beaujolais” Haricots verts & Pommes Boulanger ***Dessert***
Haringkade 6 te Katwijk aan Zee – 071 40 863 79 reserveringen@dezuid-wester.nl | www.DeZuid-wester.com



Clafoutis aux cerices “kersengebak met vanille ijs”



Vin: Beaujolais primeur 2019







€ 57,50 p.p.

071-5294922 reserveringen@brasserie-havenkwartier.nl




Op vrijdagavond van 18.30 tot 21.00 uur is er een speciale Kerstshopavond met livemuziek en leuke aanbiedingen! Kom genieten van de gezellige kerstsfeer, shop de mooiste cadeaus, en profiteer van leuke aanbiedingen. Een perfecte avond om in de feeststemming te komen!

werkplaats volledig met de hand maken, de mogelijkheden zijn dan ongelimiteerd.
Kijk op onze website of bel voor meer informatie.








WERKZAAMHEDEN n Het werk op het Wantveld vordert gestaag. Woensdag 30 oktober werd een tussenstand opgenomen door wethouder Theo Alkemade die een kijkje nam in het proces.
Door Ina Verblaauw
Er liggen nog steeds enorme kuilen met aan de oppervlakte groene buizen voor de riolering en de veel grotere infiltratiebuizen voor de opvang van regenwater. De wethouder inspecteerde één van de infiltratiebuizen. In deze buizen zijn veel kleine gaten aangebracht, die
ervoor gaan zorgen dat water snel in de bodem verdwijnt. De riolering is een gescheiden afvoersysteem, die ook vernieuwd werd.
De grootste werkzaamheden zijn onder de grond en dus onttrokken aan het oog van de weggebruiker. Maar ook boven de grond zullen er een aantal veranderingen zichtbaar worden. De stoep wordt een tegel breder, wat voor voetgangers met een rolstoel, rollator of scootmobiel een grote verbetering is. Verder worden er twee fietspaden aangelegd in rood asfalt, zodat het voor deze weggebruikers veiliger
wordt omdat er dan een voorrangsregel geldt. Deze verbreding heeft tot gevolg dat dit ten koste gaat van 35 parkeerplaatsen. Het schuin parkeren aan deze zijde van het Wantveld wordt langs parkeren oftewel achter elkaar parkeren.
2025 De werkzaamheden zullen rond de Kerst van dit jaar worden afgerond, waarna nog het stuk vanaf de Hoogwakersbosstraat tot ongeveer halverwege Theater De Muze onder handen worden genomen. Rond Pasen 2025 wordt verwacht dat het project is afgerond.
WONEN n Betaalbare woonruimte voor starters en alleenstaanden is al langere tijd een onderwerp van politieke discussie. Over oplossingen zoals tijdelijke woningen wordt veel gepraat maar concreet gebeurt er nauwelijks iets. De gemeenteraad ontving eerder deze maand een brief van de initiatiefnemers van het project Tiny Vibes die hun initiatief nog eens opnieuw onder de aandacht bracht.
Door Wim Siemerink
Deze initiatiefnemers wijzen ook weer op de lange wachtrijen voor betaalbare woningen. Daarnaast stelt men in veel gevallen bovendien een soms ontoereikende en vaak lastige mogelijkheid tot het verkrijgen van een hypotheek vast. Zij zouden de politiek meer inzicht willen verschaffen in de oplossingen die zij voor ogen hebben. Daartoe is er op 4 november een presentatie in de commissie Ruimte.
Het project Tiny Vibe’s zou mogelijk kunnen voorzien in een behoefte
voor jongeren die zelfstandig willen wonen. Zij zien een oplossing in de vorm van huur-/koop met spaarovereenkomsten als vooral de financiering het probleem is. Daarnaast rekent men op de bereidwillige eigenaren, die meewerken zodat grond tijdelijk kan worden benut. Zij zien verschillende mogelijkheden in Flexibele woonunits zoals verrijdbare huisjes of containerwoningen op diverse soms heel verschillende locaties.
Men kijkt daarbij heel positief naar de mogelijkheden die het project zou bieden en noemen het investeren in de toekomst. Men stelt: ‘Huur met optie tot koop’ en ‘lage huur stimuleren’ zorgt voor financiële stabiliteit en eigenaarschap bij jongeren; met als doel een overschot in de spaarpot voor hen te creëren.’
SAMENWERKEN
Een cruciaal aspect van het succes van Tiny Vibe Noordwijk zou volgens de initiatienemers liggen in samenwerking met verschillende belanghebbenden. Men noemt grondeigenaren, financiële instel-
In de bollenteelt heeft iedere kweker slechte herinneringen aan onkruid. Daar waren vroeger geen bestrijdingsmiddelen tegen, dus in die zin was de teelt al biologisch. Het was schoffelen of wieden geblazen. Weliswaar had de uitdrukking, dat je in de “vetwei” lag, een romantisch tintje, maar dat was het zeker niet. Wekenlang op de knietjes met een mandje voor je uit geschoven. Wat was het een feest toen in de tulpen de Chloor IPC z’n intrede deed. Het gehate “muur” verdween. Later kwamen er nog veel betere middelen. Ook de toepassing met de veldspuit verbeterde sterk. Het hardnekkigst waren de wortelonkruiden, die kan je alleen op leeg land bestrijden. Distels, kweek en kiek zijn nu met groeistoffen goed te reduceren. Ook de veel grotere plantdichtheid van de bollen draagt bij aan verlaging van de onkruid-druk. Sofar so good, er is echter een klein plantje dat knolletjes maakt en dat menig akkerbouwer en kweker hoofdpijn bezorgt, met een mooie naam genoemd cyperus esculantus. Die kleine knolletjes worden in Spanje gerooid en gegeten! De knolcyperus, zoals het genoemd wordt, is vele jaren over het hoofd gezien. Het lijkt sterk op zeebies in de slootkanten en heeft zich op bijna alle zandgronden kunnen nestelen, ook in de Bollenstreek. Voorjaarsbollen hebben er weinig last van, die worden gerooid voordat het plantje groeit. Echter, alles wat in de zomer geteeld wordt, kan er mee besmet worden.

lingen en natuurlijk de lokale overheid. Als de gemeente wil meewerken dan zou dit de basis zijn voor het creëren van extra woonvoorzieningen.
Men benadrukt dat het niet gaat om een Tiny house park, maar om 250 huisjes verspreid over diverse locaties. De huisjes zouden mogelijk 10-15 jaar kunnen blijven staan.
Men denkt dat de woningmarkt er nadien weer heel anders uit kan zien. De initiatiefnemers noemen het belangrijk dat jongeren hiermee op korte termijn zelfstandigheid kunnen ervaren en later kunnen doorstromen in de reguliere woningmarkt.
De commissie Ruimte zal deze week zeker nog geen beslissing nemen maar de initiatienemers wordt nu wel de ruimte geboden hun visie bij hen onder de aandacht te brengen.
Als er positief op gaat worden gereageerd dan volgt er de periode van politiek debat met mogelijk op termijn de besluitvorming.
Wat te doen? Je kunt in hoge nood je land omdreggen. Plantjes onder de grondwaterlijn zijn weg. Je kunt ze ook uitputten door in de zomer steeds te fraisen. Ook electrocuteren is een mogelijkheid, dan strijkt een machine ze af met 8000 Volt. De vermaledijde Round-Up werkt in ieder geval goed! Kortom, bij invasieven blijft het opletten geblazen!
Aad van Ruiten.
EVENEMENT n 4500 deelnemers deden zaterdag 2 november mee aan de 11strandentocht van de Hartstichting. Door 12,5, 25 of 50 kilometer over het zand te wandelen of rennen, haalden deelnemers ruim 272.500 euro op voor onderzoek naar hart en vaatziekten. De tickets waren in een razend tempo uitverkocht, ruim een maand voor het evenement. Naast de geweldige opkomst en de indrukwekkende opbrengst, gaven de persoonlijke verhalen en emoties deze dag een bijzondere lading.
Twan en zijn dochter Bente, die met een hartafwijking werd geboren, liepen samen de tocht. Twan vertelt: “Toen Bente net geboren was, ontdekten de artsen een ruisje in haar hart. Als ouders maak je je dan enorme zorgen, maar dankzij onderzoek is toen goed ingegrepen en kunnen we nu samen de 50 kilometer lopen.” Die ervaring liet hen inzien hoe belangrijk onderzoek naar hart- en vaatziekten is. “Geld is nodig om ook anderen te kunnen helpen zoals Bente geholpen is”, zegt Twan. “Hieraan meedoen voelt als écht iets extra’s doen.”
“Het weer, de mensen, de lachende en soms huilende gezichten – dat maakt de dag heel waardevol,” vertelt Barbara Admiraal, medeorga-
nisator namens de Hartstichting. De tocht verliep over oer-Hollandse stranden en langs allerlei stempelposten waar activiteiten werden georganiseerd. De deelnemers finishten in het centrum van Zandvoort en werden onthaald door de vele toeschouwers. “We zijn enorm trots, ook op de vrijwilligers en vooral op het prachtige bedrag dat we samen hebben opgehaald”, aldus Admiraal.
De Hartstichting heeft grote plannen voor de toekomst van de 11strandentocht. “Deze tocht moet een jaarlijks terugkerend evenement worden, net als de Nijmeegse Vierdaagse; een fysieke uitdaging en een mooi feest bij de finish,” zegt Admiraal. “Gezien het succes van dit jaar is het niet onrealistisch om volgend jaar 10.000 wandelaars en joggers aan de start te zien.”
De 11strandentocht biedt deelnemers een kans om hun eigen gezondheid te verbeteren door te wandelen, joggen of hardlopen, terwijl ze geld inzamelen voor de Hartstichting. De opbrengst van de tocht gaat naar cruciaal onderzoek om hart- en vaatziekten beter te kunnen behandelen en voorkomen. In Nederland leven 1,7 miljoen mensen met een hart- of vaatziekte, en zonder actie dreigt dat aantal in de komende jaren met één miljoen te stijgen.

Stairz heeft een compleet nieuwe vloerenstudio met alle nieuwe trends op vloerengebied. Laminaat en PVC vloeren in alle soorten en maten, van stroken tot visgraat, en van zwevend gelegde vloeren tot geplakte vloeren.
Stairz Vloeren is dé specialist op het gebied van alle harde vloeren. Wij beschikken over een vakkundig legteam dat zijn hand niet omdraait, voor het fabriceren van de mooiste vloeren!
Ook vloerverwarming is voor ons geen probleem. Vraagt u onze adviseurs naar de mogelijkheden. Wanneer uw appartement moet voldoen aan geldende normen qua geluidsisolatie bent u bij ons aan het juiste adres.
Natuurlijk kunt u bij ons stalen van de vloeren meenemen om ze thuis te bewonderen, maar ook komen wij vrijblijvend langs voor advies en inmeten van de woning.



Openingstijden showroom: Ma- Vr 8.00 – 17.00 Zaterdag 9.30 – 16.00



Actie wegens succes verlengd! Gratis gelegd! *geldig t/m december 2024

Meer en Duin 78, 2163 HC Lisse (Zuid-Holland) 0252-508000, info@stairz.nl

De persoonlijke kastenspecialist voor alle soort kasten... zelfs voor kasten met afgeschuinde hoeken!
Voor inspiratie en advies maakt u eenvoudig en kosteloos een afspraak om onze showroom te bezoeken.




woonkamerkasten wasmachinekasten




verwarmen. Zo kan 70% gas of meer worden bespaard.
All-electric
de meest kostenefficiënte manier van verwarmen. Zo kan 70% gas of meer worden bespaard.
All-electric
Met de volledig elektrische (all-electric) variant kan je gasverbruik terug naar nul. Een volledig elektrische luchtwarmtepomp levert optimaal rendement met vloerverwarming, ventilatorconvectoren of speciale radiatoren. Dit soort lagetemperatuursystemen worden in moderne woningen vaak toegepast. Een ander voordeel is dat je de warmtepomp op warme zomerdagen kan zorgen voor topkoeling, zodat je het hele jaar door een aangenaam binnen-klimaat hebt.


Subsidie warmtepomp min. € 2400,00
Subsidie zonnepanelen 100% BTW vrrij
Wij ontzorgen u volledig! Van advies tot installatie op duurzaam gebied
All electric warmtepomp
Verwarmen, koelen en warm water voor elke woning!
Met de volledig elektrische (all-electric) variant kan je gasverbruik terug naar nul. Een volledig elektrische luchtwarmtepomp levert optimaal rendement met vloerverwarming, ventilatorconvectoren of speciale radiatoren. Dit soort lagetemperatuursystemen worden in moderne woningen vaak toegepast. Een ander voordeel is dat je de warmtepomp op warme zomerdagen kan zorgen voor topkoeling, zodat je het hele jaar door een aangenaam binnen-klimaat hebt.
Wij ontzorgen u volledig!
Van advies tot installatie op duurzaam gebied

info@bernardschulte.nl • www.bernardschulte.nl
info@bernardschulte.nl • www.bernardschulte.nl


Traint én ontlast het lichaam
Hoogwaardig Zwitsers product

Unieke luchtkussenzool


Word nu lid op natuurmonumenten.nl en ontvang 4 x per jaar het magazine Puur Natuur

Postzegel- en muntenverzamelingen te koop gevraagd. Contante betaling. Ook taxaties. Telefoon 070-3388427 of 06-51118436, e-mail toorndick@gmail.com
HOUTEN VLOER SCHUREN / PARKETRENOVATIE
Schuren en afwerken van uw bestaande parket- plankenvloer. Reparatie, aanhelenbestaande vloer, onderhoud. Diverse soorten afwerkingen parketlakken, hard wax- oliën, inkleuren. Kies de afwerking die bij u past. Smaak is immers iets persoonlijks! Ook verzorgen wij de totale randafwerking nieuwe plinten, inloopmatten. Tevens ook voor het leveren en leggen van nieuwe houtenvloeren. Info? www.parketvloerenschuurservice.nl MMF Katwijk 071 333 37 00
TE KOOP; PARTIJ OUDE KERSTSPULLEN
Activeert de voet
Perfecte drukverdeling
Loopt u moeizaam door artrose, hielspoor, fatpad-syndroom, neuropathie of rugklachten? En heeft u alles al geprobeerd?
WIJ KUNNEN U HELPEN!
071 - 203 23 77
Kom gewoon langs, of maak een afspraak met de Stapvitaal fysiotherapeut en ontdek wat de schoenen van kybun voor uw kwaliteit van leven kunnen betekenen.
GRATIS fysiotherapeutisch advies mogelijk
Groene Hartplein 5 Zoeterwoude
FREDERIKSOORD
ZOETERWOUDE

oude vazen, vintage en voor de verzamelaar oude boeken Koningshuizen een oude scheepsbel. 06- 22 78 96 44.
WERKKLEDING MET UW LOGO?
Haven 4 (in de zwaaikom)
uw keuken zodat deze weer jaren mee kan!
Katwijk aan Zee 071 888 7400


HULSHORST
VEGHEL






Betaalbare TUINMAN/ STRATENMAKER heeft ruimte en tijd voor elke klus, (groot of klein). Van straatwerk & onderhoud van tuinen. Tegen scherpe prijzen maken wij het voor u in orde. J. van de Schep, bel 06-12781775 Mail: vdschep@hotmail.com
Zeer ervaren KAPSTER aan huis ! Tel: 06-12121061 Tot snel!
TUINMAN met ruime ervaring heeft ruimte en tijd voor uw tuin, groot of klein. Alle tuinwerkzaamheden en onderhoud. Ook voor straatwerk bent u bij mij aan het juiste adres. Scherpe prijzen! Gratis prijsopgave. J. de Mooij Rijnsburg, tel. 06-11848117
Te koop gevraagd: Lp’s en singels. Eerlijke prijs voor uw lp verzameling. Disco, Blues, Folk, Rock, Jazz, Klassiek en andere muziek voor mijn hobby heb ik een brede interesse. Ruimt u op, belt u mij ik bied eerlijke prijzen voor uw verzameling. Mijn mobiele nummer is; 06-13974136.

Ik renoveer uw keuken zodat deze weer jaren mee kan!

Is uw keuken toe aan vernieuwing? Ik kom graag bij u langs voor advies op maat.
KAMP JE MET PERSOONLIJKE OBSTAKELS zoals je opgebrand voelen, trauma, gebrek aan zingeving……. Kijk dan eens of PSYCHOSYNTHESE iets voor je kan betekenen. Voor meer informatie kan je een mail sturen naar lydia@lydiavangroningen.nl of kijk op mijn site: www.lydiavangroningen.nl


Ik renoveer uw keuken zodat deze weer jaren mee kan!



Is uw keuken toe aan vernieuwing? Ik kom graag bij u langs voor advies

20 % Winter Schilder Korting ! *********************************************
NOG ENKELE WEKEN BESCHIKBAAR tussen 18 november en 22 maart voor

Steven de Bondt | 06 – 45 14 82 78 | stevendebondt@dekeukenvernieuwers.nl www.dekeukenvernieuwers.nl










BINNEN SCHILDERWERK *************************************
en nog 1 week voor buiten schilderwerk ! Gedipl. VAKSCHILDER 31 jaar ervaring Bel voor een vrijbl. afspraak & prijsopgave, De Schilderexpert, Kevin Lanser, 06 523 46 277, Lageweg 37.F.5 te Katwijk
Is uw keuken toe aan vernieuwing? Ik kom graag bij u langs voor advies op maat.
KLANTEN BEOORDELINGEN & FOTO’S van opdrachten: WWW.DESCHILDEREXPERT.NL Wij zijn u graag van dienst !



Agenda 05-11-2024

Najaarslezing “De Trekvaart
Haarlem-Leiden”
De Oude Dorpskern
In de Oude Jeroenkerk, Noordwijk
8 november 20.00 - 22.00 uur
Toegang gratis Meer info www.deoudedorpskern.nl
Donny’s Pubquiz
Met Donny Roelvink
Nomade Beach House
Koningin Wilhelmina Boulevard
8 november 20.00 - 22.00 uur
Gratis met een YoungPWR account Meer info en inschrijven www.youngpwr.nl/
Klamuze - Erasmus Trio
Opening van het seizoen
In Grand Hotel Huis ter Duin
10 november vanaf 15.00 uur
Toegang € 35 incl consumpties Meer info en kaarten klamuze.nl
James Oesi & Djuwa Mroivili
BreekdeWeek in Jeroen
13 november om 20.15 uur
Toegang € 22,50
Meer info en tickets www.webwinkelmuziekinjeroen.nl
CARNAVALSVERENIGINGEN
Gala-avond Kaninefaaten
9 november 20.00 uur
Prinsbekendmaking der Noortukkers
9 november 20.30 uur
Prinsbekendmaking Duinknijnen
10 november 12.30 uur
Atlantik Wall NIEUW
Noordgang geopend
Expositie van Jeroen Rijpsma
3 november 10.30 – 16.00 uur
Reserveren verplicht
Meer info en tickets op atlantikwall.nl
Beleef het verhaal van de Engelandvaardersinteractieve game
Locatie: Museum Engelandvaarders
Dinsdag t/m zondag 10.30 – 16.30
Meer info www.museumengelandvaarders.nl
De HaarlemmertrekvaartLeidsevaart
Museum Noordwijkerhout van Toen Zeestraat 3a
Woensdag/vrijdag/zaterdag van 13.00 – 16.00 uur www.noordwijkerhoutvantoen.nl
Inloopochtend
Genootschap Oud De Zilck
13 november 9.30 uur – 12.00 uur
In De Duinpan
Meer info www.ouddezilck.nl/
Ook op de cultuuragenda?
Laat het een week voor de plaatsingsdatum weten via saskia@sportbedrijfnoordwijk.nl
Een artikel voor de cultuurpagina
moet twee weken van tevoren ingeleverd worden.
n ‘We moeten onze jongeren beschermen’
BURGEMEESTER Wendy Verkleij
heeft afgelopen weken 3 politiecontroles laten uitvoeren rondom het onverantwoord gebruik van fatbikes. “Het aantal ongevallen als gevolg van onverantwoordelijk gebruik van fatbikes stijgt in zorgwekkend tempo,” verklaart burgemeester Verkleij. “De huidige situatie is gevaarlijk en vraagt om maatregelen.”
De burgemeester bezocht vorige week een politiecontrole op de kruising Van de Mortelstraat en Gooweg. “We zien een groeiend aantal jongeren op fatbikes die zich niet aan de verkeersregels houden,” licht Wendy Verkleij toe. “Soms zitten er wel drie personen op één fatbike, vaak opgevoerd en met bestuurders die onvoorzichtig rijden. Dit maakt onze fietspaden onveilig en brengt zowel de bestuurders als andere weggebruikers in gevaar.”
Fatbikes zijn steeds populairder onder jongeren. Wendy Verkleij: “Jongeren vinden zo’n vervoermiddel aantrekkelijk. Met minimale inspanning kunnen ze hoge snelheden bereiken. Maar kinderen van 12, 13 en 14 jaar hebben nog heel weinig verkeerservaring. Zonder helm rijden ze met hoge snelheid over fietspaden en kruispunten. Dit leidt tot gevaarlijke situaties én een toename van het aantal ongevallen.”

BLIJVENDE HERSENSCHADE
Veel gemeentes en medische professionals luiden inmiddels de noodklok. “Recent onderzoek wijst op een zorgwekkend aantal van ongeveer 5000 fatbike-gerelateerde ongevallen per jaar in Nederland,” vertelt Verkleij. “Het aantal ernstige verwondingen neemt ook toe. Kinderen riskeren blijvende hersenschade door ongelukken op deze
KUNST n Het nieuwe kunstwerk moet de verbinding tussen de 4 kernen van Noordwijk verbeelden én verwijzen naar Noordwijk als heilzame badplaats.
Gemeente Noordwijk organiseert een ontwerpwedstrijd. Kunstenaars uit het hele land maken kans op de hoofdprijs. De winnaar krijgt 25.000 euro en de opdracht om het kunstwerk te maken en te plaatsen.
PROFESSIONELE ERVARING
Deelname staat open voor professionele kunstenaars met een afgeronde kunstopleiding op HBO- of academisch niveau. Ook wie aantoonbare professionele ervaring heeft in het creëren van kunstwerken in de openbare ruimte kan zich aanmelden.
DRUKKE VERKEERSROTONDE
Het kunstwerk komt te staan op de rotonde Beeklaan, Boekersloot-
laan, Bonnikeplein in Noordwijk. De rotonde ligt op de route naar de Noordzeekust. Dagelijks passeren vele bewoners en bezoekers dit drukke verkeerspunt.
SCHONE LUCHT
Het ontwerp moet inwoners en bezoekers het plezierige gevoel geven dat Noordwijk ons tijd en ruimte biedt te genieten van schone lucht, duinen en zee. Daarnaast moet het kunstwerk de internationale uitstraling van Noordwijk een boost geven.
REACTIES
De 1e selectie is op basis van het cv en afbeeldingen van eerder werk. Kunstenaars kunnen zich aanmelden via de website.
Hier staat alle informatie en de voorwaarden voor deelname. De inschrijving staat open tot 15 december 2024.

‘machines’. We moeten onze jongeren beschermen. Ze overzien de risico’s niet.”
MAATREGELEN
De gemeente Noordwijk tekende eerder een petitie waarin zij pleiten voor een minimumleeftijd van 16 jaar en een helmverplichting voor fatbike-gebruikers. Ook worden controles op opgevoerde fatbikes in
de gemeente verder aangescherpt. Wendy Verkleij: “Maar controle is slechts een deel van de oplossing. Fatbikes creëren momenteel een Wild West in het verkeer. De populariteit vraagt om landelijke maatregelen. Dit kunnen we niet laten gebeuren. Het is levensgevaarlijk en moet tot een halt worden geroepen.”
BIBLIOTHEEK n November staat bij de Bibliotheek Bollenstreek in het teken van de Groene bieb. Want een duurzaam leven kan leuk en inspirerend. Tijdens de activiteiten van de Groene bieb komen bezoekers tot nieuwe inzichten. Er kunnen ervaringen uitgewisseld worden en ideeën opgedaan worden voor een milieubewuste levensstijl. Ontdek hoe kleine stappen een grote impact kunnen hebben.
Iedereen is van harte welkom. Er zijn activiteiten voor volwassen, maar ook voor kinderen. En vergeet vooral niet even langs te lopen om de ‘groene’ boeken te ontdekken. In de bibliotheek van Noordwijk en Noordwijkerhout zijn energiespreekuren. Hier kunnen mensen terecht voor tips en adviezen over hoe bespaard kan worden op ener-
giegebruik. Tijdens de Koffie+ in de bibliotheek van Noordwijkerhout wordt de workshop Tuinieren op balkons en terrassen gegeven. Op 6 november kunnen kinderen in de bibliotheek van Noordwijkerhout onderzoek doen naar hoe schoon het water is tijdens de workshop Bont en blauwe oceanen. Op 28 november komt Jelle Derckx naar de bibliotheek van Noordwijk om zijn verhaal te vertellen over hoe op een eenvoudige manier stappen gezet kunnen worden om gelukkiger, gezonder en duurzamer te leven tijdens de lezing Verlangen naar minder.
Meer informatie over de Groene bieb is te vinden op de website van de Bibliotheek Bollenstreek www. bibliotheekbollenstreek.nl/groenebieb. Hier zijn ook kaartjes te reserveren voor de verschillende activiteiten van de Groene Bieb.
PUBQUIZ n Jongeren van 15 tot 25 jaar zijn op vrijdag 8 november welkom bij een gratis pubquiz, georganiseerd door YoungPWR in samenwerking met Noordwijk Marketing en de gemeente Noordwijk. De pubquiz vindt plaats bij Nomade Beach Club in Noordwijk aan Zee.
De avond wordt gepresenteerd door health influencer Donny Roelvink, bekend van zijn Instagramkanaal waarop hij jongeren inspireert met sport, voeding en een positieve
mindset. De quiz biedt niet alleen vermaak, maar is ook een gelegenheid voor jongeren om meer te leren over Noordwijk en om kennis te maken met ondersteuningsmogelijkheden binnen de gemeente. Jongerenwerkers van Welzijnskwartier zullen ook aanwezig zijn voor eventuele vragen of ondersteuning. De deelnemers maken kans op een van de 40 prijzen. Daarnaast ontvangt elke deelnemer na afloop een goodiebag. Jongeren kunnen zich gratis aanmelden voor de pubquiz via de website van YoungPWR.













































Uw advertentie verschijnt in de regio:
Particuliere advertenties kunnen in al onze kranten worden geplaatst.
Voor € 35,- kunt u 120 tekens plaatsen. U kunt deze tot donderdag 12.00 uur inleveren, de advertentie verschijnt dan een week later in al onze kranten.
Particuliere advertenties kunnen op onze website of tegen contante betaling op onderstaande adressen worden ingeleverd.
• UITGEVERIJ VERHAGEN, Ambachtsweg 7a, KATWIJK
• VALUTAHUIS, Voorstraat 22, KATWIJK
• PRIMERA v.d. Lans, Hoofdstraat 208, SASSENHEIM
• THE READSHOP, in de Hoftuin, RIJNSBURG
• BOEKHANDEL DE KLER, De Kempenaerstr. (Passage), OEGSTGEEST
U kunt ook de bon met contant geld in een envelop sturen naar: Uitgeverij Verhagen, Ambachtsweg 7a, 2222 AH Katwijk of via e-mail naar receptie@uitgeverijverhagen.nl
INLEVEREN TOT DONDERDAG 12.00 UUR! (plaatsing in de week daarna)


Kaptein Orthopedie is een regionale zorgaanbieder op het gebied van het oplossen van voetproblemen. Wij zijn werkzaam vanuit onze vestigingen in Noordwijkerhout en Heemstede. Centraal staat een klantgerichte aanpak bij het oplossen van voetproblemen, in nauwe samenwerking met de voorschrijvend specialist of arts. Niet alleen medisch functioneel, maar ook cosmetisch. Ter versterking van ons team zijn wij op zoek naar een
Administratief Medewerker | 16-24 uur p/w
Je ondersteunt bij administratieve werkzaamheden zoals het bijhouden van dossiers, verwerken van bestellingen en klantgegevens en het te woord staan van klanten aan de telefoon. Uiteraard doe je dit samen met andere enthousiaste collega’s.
Jij • hebt voldoende ervaring met administratief werk
• bezit organisatorische vaardigheden en bent nauwkeurig
• hebt basiskennis van kantoorsoftware zoals Word en E
| 32-40 uur p/w
Je verricht allerhande werkzaamheden in en rondom de werkplaats, ter ondersteuning van het dagelijkse productieproces van orthopedische schoenen en schoenvoorzieningen.
Jij • bent handig, gemotiveerd en weet van aanpakken
• bent in bezit een rijbewijs zodat je op logistiek vlak kan ondersteunen
• vindt het leuk om dingen te leren
• krijgt de mogelijkheid om door te groeien in het schoenmakersvak
Wij bieden jou een leuke en afwisselende functie in Noordwijkerhout met
• een enthousiast en collegiaal team om mee samen te werken
• een marktconform salaris.
Interesse? Of ken jij iemand die past bij deze functies? Neem dan contact op met Kaptein Orthopedie (0252) 34 04 61 en vraag naar Wim of Dorine Kaptein. Of stuur je motivatie en CV naar wim@kaptein-orthopedie.nl.

Katwijk Rijnsburg Valkenburg Noordwijk Noordwijkerhout De Zilk Sassenheim Voorhout Warmond
Lisse
Hillegom Beinsdorp Oegstgeest Leiderdorp incl. btw




INVULLEN IN BLOKLETTERS (spatie = hokje leeg laten, niet buiten de vakjes schrijven, vermeld ook uw telefoonnummer!)
Naam:
Adres: Tel.: € 35,-







Nieuwe Zeeweg 73a, 2202 HA Noordwijk
J. Lamberts
10 november 10.00 uur
Hoofdstraat 10, 2202 GD Noordwijk
Ds. A. Wicke 10 november 10.00 uur
Voorstraat 44, 2201 HW Noordwijk
10 november 10.00 uur
Herenweg 15 Noordwijkerhout
M. Straathof 10 november 10.00 uur



LEZEN n Vorige week is de nieuwe foto- en verhalenbundel ‘Verlangens naar toen’ gepubliceerd. Het rijk geïllustreerde boek neemt de lezer mee naar de jaren van de wederopbouw na de Tweede Wereldoorlog.
Henk van der Pol, auteur van het boek: “De originele kiekjes en foto’s die in het boek worden getoond komen uit eigen voorraad, van vrienden, uit historische archieven en, na een oproep in de krant, zelfs van volslagen onbekenden. Het was geweldig om te ervaren dat zovelen wilden bijdragen.”
Het boek is verkrijgbaar in de Nederlandse boekwinkels en voor iedereen online te bestellen op verlangensnaartoen.nl. De boeklancering vindt plaats op 7 november om 19.30 uur in boekhandel Wagner in Sassenheim.
Oplage 21.250 Verschijnt iedere dinsdag
Uitgave van: Uitgeverij Verhagen Ambachtsweg 7a 2222 AH Katwijk T (071) 402 29 01
Openingstijden:
Ma en do van 08.30 tot 17.00
uur, di tot 16:30 uur, wo tot 15:30 uur en vr tot 12.30 uur
Hoofdredactie: Marc Wonnink 06 100 895 44 marc.wonnink@uitgeverijverhagen.nl
Redactie: Elske van der Valk 06 307 912 60 redactie@denoordwijker.nl

Iedereen is welkom bij ToerFietsClub (TFC). | Foto: pr
CLUB n ‘De herfst is geen excuus om binnen te blijven zitten.’
Voorzitter Piet Groen vertelt enthousiast waarom lid worden van de toerfietsclub in de herfst, een goed idee is.
‘Fietsen is een heerlijke activiteit die je helpt bij het opbouwen van uithoudingsvermogen en het ver-
redactie@noordwijkerhoutsweekblad.nl
Correspondenten Wim Siemerink Ina Verblaauw Willem Krol
Inleveren kopij: De deadline voor het insturen van kopij is iedere vrijdag voor 11.00 uur. Insturen kan naar redactie@ denoordwijker.nl. Nagekomen stukken uitsluitend in overleg met de redactie.
Advertenties: Wanda de Mooij 06 196 974 83 Wanda.de.mooij@uitgeverijverhagen.nl Desiree Uijldert
071 40 229 01 desiree.uijldert@uitgeverijverhagen.nl
Contactgegevens Binnendienst Hennie Olthof 071 409 16 37 advertentie@uitgeverijverhagen.nl o.v.v. De Noordwijker / Noordwijkerhouts Weekblad Sluitingstijd advertenties maandag 10.00 uur.
Bezorgklachten www.uitgeverijverhagen. nl onder kopje bezorging. All-Inn Verspreidingen, 0252 251420, info@verspreidingen.nl of onder kopje bezorging.

De woorden zitten horizontaal, verticaal en diagonaal in alle richtingen in de puzzel verstopt. Ze kunnen elkaar overlappen. Zoek ze op en streep ze af. De overblijvende letters vormen achter elkaar gelezen de oplossing.
AJOUR
BAKBLIK
BESEF
BIRMA
BLOKJE
BOUILLON CANASTA CAUSEUR
COACH
DAKKAPEL
DANKFEEST
ECOMARE FONDSTITEL FRONT ITALIE
KNIKKERTJE LAKMOES LARVE LASER
LOFLIED ONBEVREESD OPPAS
OPTISCH PROPJE RANDZEE REISBUREAU ROLMOPS SCHROOT SIERSTEEN SPELLING SPRUIT
STAAFMIXER STADS
STEPPE STOEL TURFGRAVER VERAF VERNE VERVALSER VOORGOED WRAAK ZUIPLAP
sterken van je spieren. Fietsen kan een solitaire activiteit lijken, maar door lid te worden van een toerfietsclub ontmoet je andere fietsliefhebbers en maak je nieuwe vrienden.
Wil je meer weten over TFC Noordwijk? Neem dan een kijkje op de website www.tfcnoordwijk.nl
De Noordwijker en het Noordwijkerhouts Weekblad worden gratis huis-aan-huis bezorgd in de gemeente Noordwijk en is af te halen op diverse locaties.
Algemene Voorwaarden De algemene voorwaarden van Uitgeverij Verhagen B.V. zijn van toepassing en zijn gedeponeerd bij de Kamer van Koophandel. U kunt de algemene voorwaarden vinden op onze website: www.uitgeverijverhagen.nl/ algemene-voorwaarden/ Uitgeverij Verhagen behoudt zich ten aanzien van de inhoud van deze uitgave en/of website zowel het auteursrecht voor volgens artikel 15 lid 1 sub 4 van de Auteurswet als het databankrecht. Niets uit deze uitgave mag worden vermenigvuldigd zonder voorafgaande toestemming van de uitgever. www.denoordwijker.nl / www.noordwijkerhoutsweekblad.nl
Maak kans op een waardebon van 15 euro van Visspecialist Van der Marel in Noordwijk.
Mail uw oplossing uiterlijk zondag 10 november oktober samen met naam en adres naar: redactie@noordwijkerhoutsweekblad.nl.
De oplossing van vorig week was: demontabel
De winnaar is: Ans Hassing
CULTUUR n Op 16 en 17 november vindt in Noordwijk een bijzondere editie van de KunstRoute plaats, georganiseerd door Stichting KunstZiNN in samen met de Oekraïense gemeenschap in Noordwijk. Dit jaar is het thema “OverLeven,” dat tot stand kwam in samenwerking met de Oekraïense dames Julia en Anna.
Julia vluchtte samen met haar zoontje voor de oorlog in Oekraïne en zet zich sinds haar aankomst in Nederland in om de soldaten aan het front te ondersteunen, waaronder haar eigen man. Anna, theaterdirecteur in Oekraïne, bracht het indrukwekkende theaterstuk “Wij zijn hier” naar Nederland, waarin zij samen met een amateurgroep Oekraïense vrouwen het thema OverLeven vormgeeft. Deze aangrijpende voorstelling, die de impact
van de oorlog toont, wordt als afsluiting van de KunstRoute opgevoerd op zondag 17 november om 17.00 uur.
Tijdens de KunstRoute openen meer dan 30 kunstenaars hun ateliers tussen 12.00 en 17.00 uur en is er een centrale expositie in de Oude Jeroenskerk, waar elk deelnemend kunstenaar een werk tentoonstelt. Ook is er werk te zien van Oekraiense kunstenaars rond het thema OverLeven, dat te koop wordt aangeboden. Een deel van de opbrengst gaat naar de hulpactie van Julia, die levensreddende middelen voor oorlogsslachtoffers bekostigt.
De KunstRoute wordt zaterdag om 12.00 uur feestelijk geopend in de Oude Jeroenskerk en is beide dagen gratis toegankelijk. Meer informatie: www.kunstzinnoordwijk.nl
LEZING n Fotogroep X65 verwelkomt op dinsdag 19 november fotografe Karin de Bruin voor een lezing over haar werk. De lezing vindt plaats in Het Trefpunt aan de Schoolstraat 2 in Noordwijk en is voor iedereen gratis toegankelijk.
Karin de Bruin, woonachtig in Hellevoetsluis, begon ooit als enthousiaste amateur en kreeg via Instagram al snel opdrachten van bedrijven en particulieren. Inmiddels heeft zij van haar hobby haar beroep gemaakt en geeft zij ook diverse fotoworkshops. Haar werk wordt gekenmerkt door het ge-
bruik van lange sluitertijden, waardoor de beelden verstild lijken en kleuren extra intens overkomen. Als landschapsfotograaf vindt Karin vaak inspiratie aan het water. Haar foto’s bevatten vaak elementen als paaltjes, stokken of bomen in het water, wat haar werk een herkenbare stijl geeft.
Tijdens de lezing vertelt Karin aan de hand van haar foto’s over haar werkwijze, van voorbereiding tot nabewerking. De avond begint om 20.00 uur, met inloop vanaf 19.45 uur. Belangstellenden kunnen zich aanmelden via het contactformulier op de website van Fotogroep X65: www.fotogroepx65.nl.

Lekker onder je warme dekbed kruipen én goed slapen met een extra november korting van... ...op boxspringsets * , matrassen, dekbedden, kussens én overtreksets.





































*Actie in de hele maand november geldt niet voor de boxspring Eastborn GO.